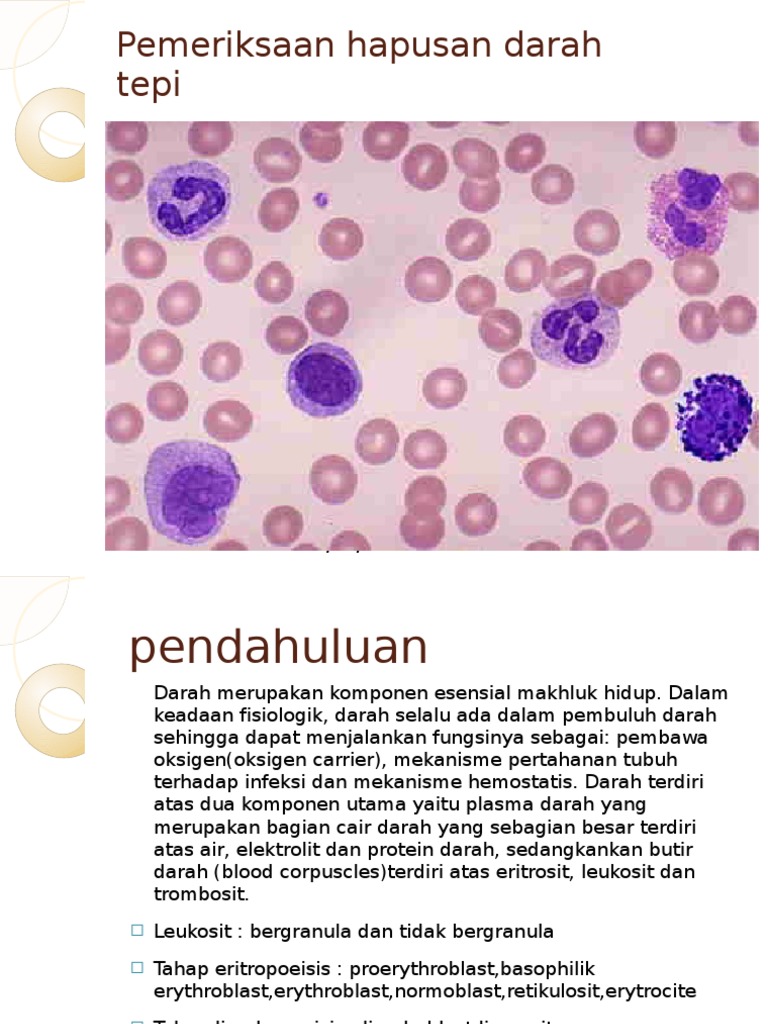

LEUKOSIT (Sel Darah Putih) Disusun Oleh : ANNISA RIZQI DAMYANTI - ppt download
LEUKOSIT (Sel Darah Putih) Disusun Oleh : ANNISA RIZQI DAMYANTI - ppt download
 Biology Educations: Macam-macam Sel darah putih (Leukosit)
Biology Educations: Macam-macam Sel darah putih (Leukosit)
 Blog Mahasiswa: Sel Darah Putih ( Leukosit )
Blog Mahasiswa: Sel Darah Putih ( Leukosit )
 LEUKOSIT (Sel Darah Putih) Disusun Oleh : ANNISA RIZQI DAMYANTI - ppt download
LEUKOSIT (Sel Darah Putih) Disusun Oleh : ANNISA RIZQI DAMYANTI - ppt download
 KUNCUP BIO: LEUKOSIT (SEL DARAH PUTIH)
KUNCUP BIO: LEUKOSIT (SEL DARAH PUTIH)
 sel darah putih yang sitoplasmanya bergranula yaitu - Brainly.co.id
sel darah putih yang sitoplasmanya bergranula yaitu - Brainly.co.id
 Leukosit memiliki bentuk yang beraneka ragam.sebutkan dan sertakan gambarnya! - Brainly.co.id
Leukosit memiliki bentuk yang beraneka ragam.sebutkan dan sertakan gambarnya! - Brainly.co.id
 Perbedaan Granulosit dan Agranulosit
Perbedaan Granulosit dan Agranulosit
 Kelas 08 smp ilmu pengetahuan alam ipa s1 siswa 2017 by P’e Thea - issuu
Kelas 08 smp ilmu pengetahuan alam ipa s1 siswa 2017 by P’e Thea - issuu
 Fungsi Sel Darah Putih Eritrosit Manusia
Fungsi Sel Darah Putih Eritrosit Manusia
 Fadhila Alizza: Sel-sel Darah
Fadhila Alizza: Sel-sel Darah

 Basofil, Bagian Sel Darah Putih yang Berperan dalam Reaksi Alergi
Basofil, Bagian Sel Darah Putih yang Berperan dalam Reaksi Alergi
 pola-pola: 03/14/14
pola-pola: 03/14/14
 Basofil, Bagian Sel Darah Putih yang Berperan dalam Reaksi Alergi
Basofil, Bagian Sel Darah Putih yang Berperan dalam Reaksi Alergi
 Diapedesis Terjadi di Leukosit Granula atau Leukosit Agranula? Halaman all - Kompasiana.com
Diapedesis Terjadi di Leukosit Granula atau Leukosit Agranula? Halaman all - Kompasiana.com
granulosit dan agranulosit - My home (biology)
granulosit dan agranulosit - My home (biology)
 PPT Komposisi darah dan golongan darah
PPT Komposisi darah dan golongan darah
6 BAB II TINJAUAN PUSTAKA 2.1. Leukosit Leukosit merupakan sel darah putih yang diproduksi oleh jaringan hemopoetik untuk jenis
 20.becik anggitani
20.becik anggitani
 Sistem Peredaran Darah | Biologi Sejati
Sistem Peredaran Darah | Biologi Sejati
 Basofil, Bagian Sel Darah Putih yang Berperan dalam Reaksi Alergi
Basofil, Bagian Sel Darah Putih yang Berperan dalam Reaksi Alergi
6 BAB II TINJAUAN PUSTAKA 2.1. Leukosit Leukosit merupakan sel darah putih yang diproduksi oleh jaringan hemopoetik untuk jenis
 186135689 Proses Pembentukan Sel Darah
186135689 Proses Pembentukan Sel Darah
 Komposisi Darah | Science Booth
Komposisi Darah | Science Booth
 LEUKOSIT (Sel Darah Putih) Disusun Oleh : ANNISA RIZQI DAMYANTI - ppt download
LEUKOSIT (Sel Darah Putih) Disusun Oleh : ANNISA RIZQI DAMYANTI - ppt download
 Perbedaan Granulosit dan Agranulosit
Perbedaan Granulosit dan Agranulosit
 Pras Academy - SMP: Sistem Transportasi pada Manusia
Pras Academy - SMP: Sistem Transportasi pada Manusia
 sistem sirkulasi Flashcards | Chegg.com
sistem sirkulasi Flashcards | Chegg.com

 Soal Postest Praktikum Sel-Sel Darah Sediaan apus darah dalam
Soal Postest Praktikum Sel-Sel Darah Sediaan apus darah dalam
 Susunan Darah Dan Fungsi Sistem Peredaran Darah manusia Terlengkap – Pelajaran Sekolah Online
Susunan Darah Dan Fungsi Sistem Peredaran Darah manusia Terlengkap – Pelajaran Sekolah Online
 Fungsi Sel Darah Putih Eritrosit Manusia
Fungsi Sel Darah Putih Eritrosit Manusia
 cairan darah terdiri atas a Zat Pelarut 90 air b Zat terlarut 8 protein yang | Course Hero
cairan darah terdiri atas a Zat Pelarut 90 air b Zat terlarut 8 protein yang | Course Hero
 Proses Pembentukan Sel Darah
Proses Pembentukan Sel Darah

 Leukimia.docx - [DOCX Document]
Leukimia.docx - [DOCX Document]
 Fungsi dan Ciri-Ciri dari Jenis-Jenis Sel Darah Putih (Leukosit) - Definisi Pengertian Secara Umum Adalah
Fungsi dan Ciri-Ciri dari Jenis-Jenis Sel Darah Putih (Leukosit) - Definisi Pengertian Secara Umum Adalah
5 BAB 2 TINJAUAN PUSTAKA 2.1 Jejas sel Sel adalah unit terkecil yang menunjukkan semua sifat dari kehidupan. Aktifitasnya memer
6 BAB II TINJAUAN PUSTAKA 2.1. Leukosit Leukosit merupakan sel darah putih yang diproduksi oleh jaringan hemopoetik untuk jenis
 tolong di jawab ya no. 1 terima kasih - Brainly.co.id
tolong di jawab ya no. 1 terima kasih - Brainly.co.id
 Sel Darah Merah, Putih, dan Keping Darah (Eritrosit, Leukosit, dan Trombosit)
Sel Darah Merah, Putih, dan Keping Darah (Eritrosit, Leukosit, dan Trombosit)
 Catatan tentang Darah - biologi smp SMP - Clear
Catatan tentang Darah - biologi smp SMP - Clear
 Sel Darah Putih - Pengertian, Kekurangan, Jenis Ciri Dan Gambar
Sel Darah Putih - Pengertian, Kekurangan, Jenis Ciri Dan Gambar
 Leukosit: Pengertian, ciri-ciri, jenis dan fungsinya | Biologi | Hisham.id
Leukosit: Pengertian, ciri-ciri, jenis dan fungsinya | Biologi | Hisham.id
 Darah mengalir karena kekuatan yang disebabkan oleh kontraksi ventrikel kiri | Course Hero
Darah mengalir karena kekuatan yang disebabkan oleh kontraksi ventrikel kiri | Course Hero

 Proses Pembentukan Sel Darah
Proses Pembentukan Sel Darah
 Free Documents
Free Documents
 BAB II TINJAUAN PUSTAKA. jenis tak bergranula (mononuklear), berfungsi dalam sistem pertahanan tubuh - PDF Download Gratis
BAB II TINJAUAN PUSTAKA. jenis tak bergranula (mononuklear), berfungsi dalam sistem pertahanan tubuh - PDF Download Gratis
 Bab 7. sistem peredaran darah
Bab 7. sistem peredaran darah
Komposisi Darah Dalam Tubuh Manusia - SIPAT
 Cairan Darah pada Sistem Sirkulasi - Tulisan Fadillah Arsa
Cairan Darah pada Sistem Sirkulasi - Tulisan Fadillah Arsa
 Perbandingan hasil pemeriksaan kadar hematokrit mikro pada darah yang
Perbandingan hasil pemeriksaan kadar hematokrit mikro pada darah yang
 Anatomi Dan Fisiologi Sistem Hematologi
Anatomi Dan Fisiologi Sistem Hematologi
 JARINGAN IKAT Mata Kuliah: Struktur Perkembangan Hewan - ppt download
JARINGAN IKAT Mata Kuliah: Struktur Perkembangan Hewan - ppt download
 DOC) DARAH | Muhamad Nurhasan - Academia.edu
DOC) DARAH | Muhamad Nurhasan - Academia.edu
 Biopsychology Task (Circulatory System) - Docsity
Biopsychology Task (Circulatory System) - Docsity
7 BAB II TINJAUAN PUSTAKA 1.1. Tinjauan Umum Darah 1.1.1. Definisi Darah Darah adalah jaringan tubuh yang yang berbeda dengan ja
BAB II TINJAUAN PUSTAKA 2.1. Barang bukti Forensik Bidang forensik dikenal motto yang menyatakan tidak ada peristiwa kejahatan y
 Sel Darah Merah, Putih, dan Keping Darah (Eritrosit, Leukosit, dan Trombosit)
Sel Darah Merah, Putih, dan Keping Darah (Eritrosit, Leukosit, dan Trombosit)
 Sistem Peredaran Darah | Biologi Sejati
Sistem Peredaran Darah | Biologi Sejati
 DOC) Fungsi Sel Darah Putih | Vera Harmeliaa - Academia.edu
DOC) Fungsi Sel Darah Putih | Vera Harmeliaa - Academia.edu
TUJUAN a. Mempelajari bentuk dan struktur sel hewan dan sel tumbuhan b. Mempelajari perbedaan sel hewan dan sel tumbuhan . DAS
 ANFISMAN (SISTEM DARAH).pdf - TUGAS MAKALAH SISTEM DARAH ANATOMI DAN FISIOLOGI MANUSIA disusun oleh Tri Handayani I1C015018 Mahrani Dewi Azka Karimah | Course Hero
ANFISMAN (SISTEM DARAH).pdf - TUGAS MAKALAH SISTEM DARAH ANATOMI DAN FISIOLOGI MANUSIA disusun oleh Tri Handayani I1C015018 Mahrani Dewi Azka Karimah | Course Hero
TINJAUAN PUSTAKA
 BAB II TINJAUAN PUSTAKA. Sel darah putih ( lekosit ) rupanya bening dan tidak berwarna, bentuknya lebih besar - PDF Free Download
BAB II TINJAUAN PUSTAKA. Sel darah putih ( lekosit ) rupanya bening dan tidak berwarna, bentuknya lebih besar - PDF Free Download
 Sistem Peredaran Darah (Sirkulasi) - Pengertian, Fungsi dan Kelainannya
Sistem Peredaran Darah (Sirkulasi) - Pengertian, Fungsi dan Kelainannya
 SISTEM PEREDARAN DARAH MANUSIA 1. Struktur dan Fungsi
SISTEM PEREDARAN DARAH MANUSIA 1. Struktur dan Fungsi
 Catatan tentang Darah - biologi smp SMP - Clear
Catatan tentang Darah - biologi smp SMP - Clear

LAPORAN PENDAHULUAN A. Anatomi dan Fisiologi Ginjal Masing-masing ginjal mempuyai panjang kira-kira 12 cm dan lebar 2,5 cm pada
 apa saja komponen utama darah manusia?jelaskan masing masing fungsinya - Brainly.co.id
apa saja komponen utama darah manusia?jelaskan masing masing fungsinya - Brainly.co.id
 Proses Pembentukan Sel Darah
Proses Pembentukan Sel Darah
KARYA TULIS ILMIAH GAMBARAN JUMLAH LEUKOSIT PADA PENDERITA TUBERKULOSIS PARU SEBELUM DAN SESUDAH DUA BULAN MENGONSUMSI OBAT ANT
6 BAB II TINJAUAN PUSTAKA 2.1. Leukosit Leukosit merupakan sel darah putih yang diproduksi oleh jaringan hemopoetik untuk jenis
 Bab 7. sistem peredaran darah
Bab 7. sistem peredaran darah
 Fungsi Sel Darah Putih Eritrosit Manusia
Fungsi Sel Darah Putih Eritrosit Manusia
Segmentasi Inti Sel Darah Putih Berdasarkan Algoritma Watershed dan Pattern Recognation dengan Slope Histogram
 Cairan Darah pada Sistem Sirkulasi - Tulisan Fadillah Arsa
Cairan Darah pada Sistem Sirkulasi - Tulisan Fadillah Arsa
 Sel Darah Putih - Pengertian, Kekurangan, Jenis Ciri Dan Gambar
Sel Darah Putih - Pengertian, Kekurangan, Jenis Ciri Dan Gambar
 Proses Pembentukan Sel Darah
Proses Pembentukan Sel Darah
 Sistem peredaran darah
Sistem peredaran darah
 Page 6 – BUKU ONLINE | Jurus Ampuh Lulus Ujian Semua Jenjang
Page 6 – BUKU ONLINE | Jurus Ampuh Lulus Ujian Semua Jenjang
 Susunan Darah Dan Fungsi Sistem Peredaran Darah manusia Terlengkap – Pelajaran Sekolah Online
Susunan Darah Dan Fungsi Sistem Peredaran Darah manusia Terlengkap – Pelajaran Sekolah Online
 KD Kelas 11 SMA a Pages 151 - 200 - Flip PDF Download | FlipHTML5
KD Kelas 11 SMA a Pages 151 - 200 - Flip PDF Download | FlipHTML5
BAB II TINJAUAN PUSTAKA 2.1. Barang bukti Forensik Bidang forensik dikenal motto yang menyatakan tidak ada peristiwa kejahatan y
 IV. HASIL DAN PEMBAHASAN. Pada penelitian hematologi darah dari 7 jenis ikan yang - PDF Download Gratis
IV. HASIL DAN PEMBAHASAN. Pada penelitian hematologi darah dari 7 jenis ikan yang - PDF Download Gratis
 Sistem Peredaran Darah pada Manusia: Pengertian Darah, Fungsi Darah, Sel Darah Merah, Sel Darah Putih, Alat Peredaran Darah dan Pembuluh Darah dan Golongan Darah - Berpendidikan.Com
Sistem Peredaran Darah pada Manusia: Pengertian Darah, Fungsi Darah, Sel Darah Merah, Sel Darah Putih, Alat Peredaran Darah dan Pembuluh Darah dan Golongan Darah - Berpendidikan.Com
 Osteon Hematologi Mid - [DOCX Document]
Osteon Hematologi Mid - [DOCX Document]
 Leukosit: Pengertian, ciri-ciri, jenis dan fungsinya | Biologi | Hisham.id
Leukosit: Pengertian, ciri-ciri, jenis dan fungsinya | Biologi | Hisham.id
 Fungsi dan Macam-macam Sel Darah
Fungsi dan Macam-macam Sel Darah
 DOC) 7. LAPRAK FISHEW DIFERENSIAL LEUKOSIT.docx | Anjar Sari - Academia.edu
DOC) 7. LAPRAK FISHEW DIFERENSIAL LEUKOSIT.docx | Anjar Sari - Academia.edu
 186135689 Proses Pembentukan Sel Darah
186135689 Proses Pembentukan Sel Darah
 A. PENDAHULUAN - SISTEM SIRKULASI
A. PENDAHULUAN - SISTEM SIRKULASI
ANFIS SISTEM HEMATOLOGI
PEMERINTAH PROVINSI BALI
GAMBARAN MODIFIKASI AIR PERASAN JERUK NIPIS (Citrus aurantifolia Swingle) sebagai PENGGANTI KOMPOSISI LARUTAN TURK untuk HITUNG
 SISTEM PEREDARAN DARAH MANUSIA IPA-8 – SMP Islam Ngadirejo
SISTEM PEREDARAN DARAH MANUSIA IPA-8 – SMP Islam Ngadirejo
Sel Darah Putih Yang Bergranula Terdiri Atas
Jan 27, 2021